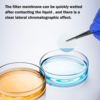

100PCS PTFE Hydrophilic/Hydrophobicity Membrane Filters Round Mixed Cellulose Esters Filter Paper 13/25/50mmDiameter 0.22/0.45um
1.Product material: PTFE/MCE/Nylon
2.PTFE:PTFE filter membrane is made of expanded polytetrafluoroethylene (PTFE) with excellent chemical compatibility. PTFE hydrophilic membrane is mainly used for liquid filtration, while PTFE hydrophobic membrane has strong hydrophobicity, which can effectively prevent water molecules from passing through while maintaining good permeability of gas molecules, ensuring the balance of filtration efficiency and air permeability.
3.13/25/50mm diameter, 0.22µm/45µm pore size filter paper. Boxed with lid for neat storage and easy access. Each box contains 100 sheets, which is more than enough for your needs.
4.MCE:MCE Filter Membrane is suitable for applications requiring high efficiency filtration due to its special structure and material and high filtration speed. The membrane is very thin and has a smooth surface, which helps to minimize resistance during the filtration process, which helps to minimize resistance during the filtration process and maintains the purity of the filtered material.
5.13/25/50mm diameter, 0.22µm/45µm pore size filter paper. 200 sheets, more than enough for your needs. Boxed with lid for neat storage and easy access.
6.Nylon :Nylon membrane has good hydrophilicity, which can quickly wet and keep the medium smooth, reduce pressure loss and improve filtration efficiency. Nylon membrane has uniform pore size, high porosity, thin texture, low resistance, fast flow rate, no media shedding, fast filtration speed, high mechanical strength (with polyethylene support layer)
7.13/25/50mm diameter, 0.22µm/45µm pore size filter paper. Boxed with lid for neat storage and easy access. 100 sheets per box is plenty to meet your needs.






4 GREAT REASONS TO BUY FROM US:
- Over 37,000 happy customers worldwide
- Real people on our support team ready to help
- The finest materials and stunning design — all our products are developed with an obsessive dedication to quality, durability, and functionality
- We use the most secure online ordering systems on the market, and are constantly improving our software to make sure we offer the highest possible security
BUY WITH CONFIDENCE
Our mission is to make your shopping experience as safe and enjoyable as possible. Have questions? Feel free to contact our award-winning customer care team for advice on everything from product specifications to order tracking.
- Money back guarantee: Something not quite right? If you’re not totally satisfied with your purchase, you can return it within 15 days for a full refund
- Risk-Free Purchase: We utilize industry-standard Secure Sockets Layer (SSL) technology to allow for the encryption of all the sensitive information, so you can be sure your details are completely safe with us
- Trustworthy payment method: We partner with the most popular online payment solutions that guarantee enhanced security and fast transaction processing